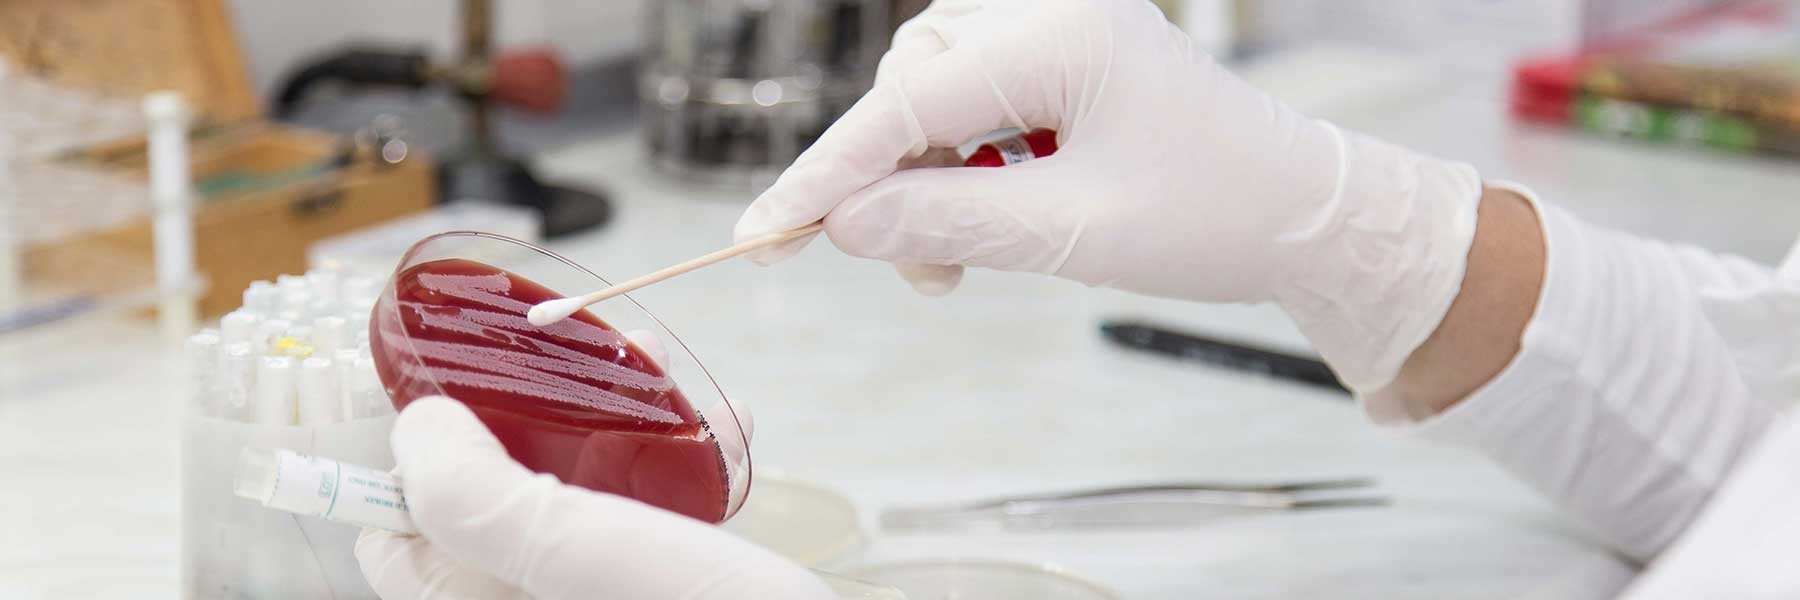
Terms and Conditions

PMT(GB) LTD
Terms and Conditions
Terms and Conditions
These Terms and Conditions, together with any and all other documents referred to herein, set out the terms of use under which you may use this website, www.pmtgb.com (our main website) or www.pmtgbshop.com (our e-commerce site) (“Our Site”).
Please read these Terms and Conditions carefully and ensure that you understand them. Your agreement to comply with and be bound by these Terms and Conditions is deemed to occur upon your first use of Our Site. If you do not agree to comply with and be bound by these Terms and Conditions, you must stop using Our Site immediately.
You can view our Website Terms and Conditions here.